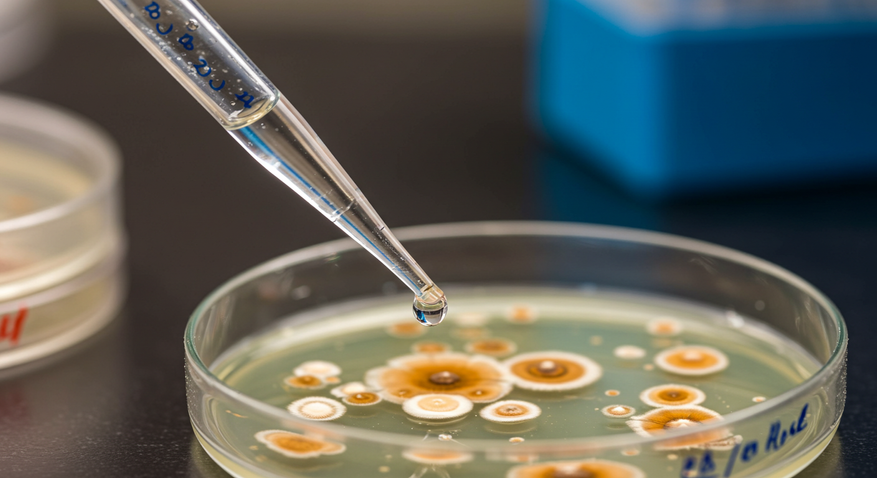

Лесные марионетки: как гриб Ophiocordyceps превращает муравьёв в зомби
В густых тропических лесах, где жизнь бьёт ключом, скрывается один из самых удивительных и пугающих паразитов природы — гриб Офиокордицепс односторонний (Ophiocordyceps unilateralis). Этот микроорганизм способен захватывать тело муравья, превращая его в послушного «зомби», который действует в интересах гриба. Его история напоминает сценарий фантастического триллера, но всё происходит в реальном мире.

Как этот гриб манипулирует насекомыми, почему он так эффективен и представляет ли он угрозу для человека? Давайте разберёмся.
Жизнь гриба: от споры до зомби
Офиокордицепс односторонний — паразитический гриб из семейства Clavicipitaceae, специализирующийся на муравьях-плотниках, особенно на виде Camponotus leonardi. Его жизненный цикл начинается с микроскопической споры, которая оседает на экзоскелете муравья, когда тот пробирается по лесной подстилке. Спора прикрепляется к телу насекомого и проникает внутрь, используя ферменты, такие как хитинза, липаза и протеаза, а также механическое давление, чтобы преодолеть защитный слой муравья.

Внутри тела насекомого гриб формирует гифы — нитевидные структуры, которые образуют мицелий. Этот мицелий распространяется, поглощая ткани и питательные вещества муравья. Через 4-10 дней гриб достигает финальной стадии: из шеи мёртвого муравья вырастает тёмный, тонкий стебель — строма, на которой формируются спороносные структуры. Эти структуры выпускают новые споры, готовые заразить следующую жертву. Удивительно, но гриб не просто убивает муравья — он манипулирует его поведением, заставляя выполнять действия, которые обеспечивают паразиту идеальные условия для размножения.
Манипуляция поведением: как муравей становится «зомби»
Заражённый муравей ведёт себя необычно. Вместо того чтобы продолжать работу в колонии, он покидает гнездо и отправляется в путешествие, которое заканчивается на растении, обычно на высоте около 25 сантиметров над землёй. Там муравей с невероятной силой впивается челюстями в лист или стебель, оставляя характерные следы в форме гантели. Это поведение, известное как «смертельный захват», фиксирует муравья на месте, чтобы он не упал после смерти.
Гриб выбирает для муравья место с высокой влажностью (94-95%) и температурой 20-30 °C — идеальные условия для роста и распространения спор. Учёные обнаружили, что гриб не повреждает мозг муравья, а действует через мышечные ткани, заменяя их собственными клетками. Эти клетки образуют сеть, которая контролирует движения насекомого. Гриб выделяет метаболиты, такие как сфингозин и гуанидинобутировая кислота, которые вызывают судороги и изменения в поведении муравья, заставляя его выполнять нужные паразиту действия.
Интересно, что гриб действует синхронно с окружающей средой. Например, в Таиланде учёные заметили, что «смертельный захват» происходит в полдень, когда солнечный свет и влажность создают оптимальные условия для гриба. После смерти муравья гриб укрепляет его экзоскелет и выделяет антимикробные вещества, защищая тело от конкурентов, пока не завершится процесс спороношения.
Эволюция и разнообразие: гриб, адаптированный к хозяевам
Офиокордицепс односторонний распространён в тропических лесах Бразилии, Таиланда, Австралии, а также в умеренных регионах, таких как Южная Каролина, Флорида и Япония. Его разнообразие объясняется адаптацией к различным видам муравьёв. Например, основная группа гриба (O. unilateralis core clade) заражает муравьёв Camponotini, вызывая у них характерный «смертельный захват» на листьях. В то же время подгруппа O. kniphofioides, обитающая в Амазонии, паразитирует на местных муравьях, которые умирают у основания деревьев среди мха, без типичного захвата листа.

Такое разнообразие связано с эволюцией гриба, который приспосабливался к конкретным видам хозяев в разных регионах. Учёные считают, что гриб выработал уникальные метаболиты для каждого вида муравьёв, что позволяет ему эффективно манипулировать их поведением. Например, виды муравьёв, не являющиеся основными хозяевами, могут погибать от инфекции, но без изменений в поведении, что говорит о высокой специфичности гриба.
Следы в прошлом: гриб с древней историей
Офиокордицепс односторонний — не новичок на планете. В Германии, в карьере Мессель, учёные нашли окаменелость листа возрастом 48 миллионов лет с характерными следами «смертельного захвата». Это доказывает, что гриб манипулировал муравьями задолго до появления человека. Такие находки помогают понять, как паразит эволюционировал, чтобы стать столь эффективным в своём деле. Они также показывают, что природа уже миллионы лет совершенствует механизмы взаимодействия между паразитами и их хозяевами.
Угроза для человека: мифы и реальность
Идея о том, что гриб, превращающий муравьёв в зомби, может заразить человека, вдохновила создателей фильмов, таких как «Новая эра Z», и книг, вроде «Ниже нуля». Однако в реальности Офиокордицепс односторонний не представляет угрозы для человека. Его споры адаптированы к заражению насекомых, а человеческий организм слишком сложен для этого паразита. Кроме того, гриб требует специфических условий — высокой влажности и температуры, которые не характерны для человеческого тела.

Даже среди муравьёв гриб не всегда успешен: лишь около 5% спор выживают и заражают новых хозяев. Природа держит паразита под контролем, не позволяя ему стать слишком разрушительным. Таким образом, людям не стоит бояться «зомби-гриба», но его изучение может принести пользу в других областях.
Медицинский потенциал: от паразита к лекарству
Несмотря на свою зловещую репутацию, Офиокордицепс односторонний привлекает внимание учёных благодаря своим уникальным свойствам. Гриб производит вторичные метаболиты, которые обладают потенциалом в медицине. Например, производные нафтохинона, выделяемые грибом, показали активность против малярии, рака и бактериальных инфекций. Эти вещества также используются как натуральные красители для пищевой и косметической промышленности, так как они устойчивы к кислотам, щелочам и свету.
Гриб также синтезирует поликетиды — соединения, применяемые в производстве антибиотиков, противогрибковых препаратов и лекарств для снижения холестерина. В традиционной восточной медицине родственные виды кордицепса, такие как Ophiocordyceps sinensis, используются для укрепления иммунитета, повышения выносливости и адаптации к стрессу. Экстракты гриба добавляют в косметику для стимуляции выработки коллагена и защиты кожи от старения.
Однако использование кордицепса требует осторожности:
- Возможны аллергические реакции: зуд, сыпь, проблемы с желудком.
- Противопоказан при нарушениях свёртываемости крови или приёме антикоагулянтов.
- Не рекомендуется беременным женщинам и детям без консультации врача.
Превышение дозировки может вызвать расстройства пищеварения, изменения давления или снижение уровня сахара в крови.
Загадки гриба: что ещё предстоит узнать
Учёные до сих пор не разгадали все тайны Офиокордицепса одностороннего. Как именно гриб заставляет муравья подниматься на растение? Одна гипотеза предполагает, что он выделяет белки, которые косвенно влияют на сенсорные функции мозга муравья, направляя его к нужному месту. Другая теория говорит, что гриб использует сохранившиеся способности муравья, позволяя ему самому выбрать подходящую «площадку» для размножения паразита.
Исследования показывают, что гриб может подстраиваться под суточные ритмы: некоторые его гены активны днём, другие — ночью, что помогает ему эффективно контролировать хозяина. Эти открытия открывают перспективы для создания новых биологически активных соединений, которые могут стать основой для лекарств. Кто знает, возможно, в будущем гриб поможет раскрыть секреты управления нервной системой, что приведёт к прорывам в медицине и нейробиологии.
Офиокордицепс односторонний — это не только пугающий паразит, но и пример удивительной изобретательности природы. Его способность манипулировать муравьями поражает воображение, а потенциал в медицине делает его объектом интереса учёных. Этот маленький гриб напоминает нам, что даже в самых крошечных организмах скрываются большие тайны, которые ждут своего часа, чтобы быть раскрытыми.
Источник: Локальная модель Flux











0 комментариев
Добавить комментарий